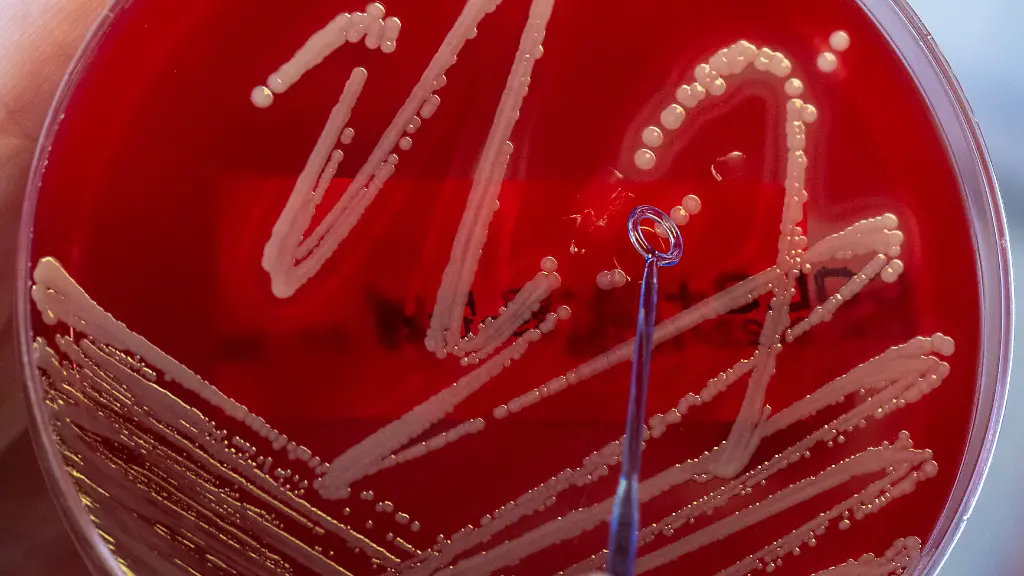
311771372

7,7 Millionen Tote pro JahrBakterielle Infektion ist zweithäufigste Todesursache
Blutvergiftung, Streptokokken, Staphylokokken: Bakterielle Infektionen können tödlich enden. Weltweit gehören sie zu den häufigsten Todesursachen. Besonders problematisch ist in dem Zusammenhang die steigende Resistenz gegen Antibiotika und damit der schwierige Kampf gegen multiresistente Erreger.
Bakterielle Infektionen waren zuletzt die weltweit zweithäufigste Todesursache und standen mit einem von acht Todesfällen in Zusammenhang. Zu diesem Ergebnis kommt eine im Fachblatt "The Lancet" veröffentlichte internationale Analyse, die sich auf Daten aus dem Jahr 2019 bezieht.
Die Studie liefert zum ersten Mal globale Schätzungen der Sterblichkeit im Zusammenhang mit 33 häufigen bakteriellen Krankheitserregern und elf Hauptinfektionsarten, die zum Tod durch Sepsis (im Volksmund auch Blutvergiftung) führen. Die Schätzungen wurden auf Grundlage von 343 Millionen Einzeldatensätzen erstellt.
13,6 Prozent aller Todesfälle weltweit
Die Analyse legt nahe, dass die 33 untersuchten Erreger 2019 für 7,7 Millionen oder 13,6 Prozent aller weltweiten Todesfälle verantwortlich waren. Mehr als die Hälfte davon entfiel auf fünf Erreger: Staphylococcus aureus (1,1 Millionen Todesfälle), Escherichia coli (950.000), Streptococcus pneumoniae (829.000), Klebsiella pneumoniae (790.000) und Pseudomonas aeruginosa (559.000).
Welcher Erreger die meisten Todesfälle verursacht, ist je nach Altersgruppe unterschiedlich. So war S. aureus bei Erwachsenen über 15 Jahren mit den meisten Todesfällen verbunden, bei Kindern zwischen 5 und 14 Jahren Salmonella enterica serovar Typhi, bei Kindern bis fünf Jahren S. pneumoniae und bei Neugeborenen K. pneumoniae.
Sterblichkeitsrate je nach Weltregion
Die Sterblichkeitsrate variierte der Studie zufolge zudem stark nach Weltregion. Sie war im subsaharischen Afrika mit 230 Toten je 100.000 Einwohnern am höchsten und in Regionen mit hohem Einkommen, konkret Westeuropa, Nordamerika und Australasien, mit durchschnittlich 52 Toten je 100.000 Einwohnern am niedrigsten.
Für Deutschland listen die Autorinnen und Autoren der Studie gut 21.000 Todesfälle in Zusammenhang mit S. aureus auf, was das Bakterium neben E. coli hierzulande zum häufigsten Erreger bei tödlich verlaufenden bakteriellen Infektionen macht.
Die Forscher stellten bei ihrer Analyse fest, dass abhängig von der Weltregion unterschiedliche Erreger den größten Einfluss auf die Sterblichkeit haben: Während S. aureus 23 Prozent der untersuchten Todesfälle in der Superregion mit hohem Einkommen verursachte, waren es nur fünf Prozent der Todesfälle in der Superregion subsaharisches Afrika.
"Diese Abweichung hat tiefgreifende Auswirkungen auf die empirische Behandlung von Infektionen, wenn der verantwortliche Erreger noch nicht identifiziert wurde und die Breite der medikamentösen Abdeckung gegen das Risiko einer Antibiotikaresistenz abgewogen werden muss", schreiben die Autoren.
Bedeutung von Antibiotikaresistenzen
Die Bedeutung von Antibiotikaresistenzen war erst kürzlich auch von der EU-Gesundheitsbehörde ECDC unterstrichen worden: Diese veröffentlichte Schätzungen, denen zufolge zwischen 2016 und 2020 jährlich mehr als 35.000 Menschen im Europäischen Wirtschaftsraum aufgrund derartiger Resistenzen verstarben. Schon im Juli hatte die Europäische Behörde für die Krisenvorsorge und -reaktion bei gesundheitlichen Notlagen der Kommission (HERA) antimikrobielle Resistenzen zu einer der drei größten Gesundheitsgefahren erklärt, welche Koordinierungsmaßnahmen auf EU-Ebene erfordern.
In Deutschland erkranken nach Angaben des Robert-Koch-Instituts (RKI) jedes Jahr etwa 50.000 Menschen an antibiotikaresistenten Erregern. "Davon sind circa zwei Drittel im Krankenhaus erworbene Erkrankungen", erklärte Tim Eckmanns, Leiter der Surveillance von Antibiotikaresistenz beim RKI, vergangene Woche. Etwa 2500 vom RKI erfasste Todesfälle gebe es jedes Jahr durch multiresistente Erreger.
In einer im Januar veröffentlichten Studie hatten die Autoren der nun in "Lancet" erschienenen Analyse bereits berechnet, dass die Zahl der Todesfälle durch resistente Erreger 2019 weltweit bei etwa 1,3 Millionen Menschen lag, wobei die Todesrate in Subsahara-Afrika und Südasien am höchsten war. Beide Studien zusammen legten nahe, dass regionsspezifische empirische Antibiotikaempfehlungen sinnvoll seien, schreiben die Forscher. Zudem sei es wichtig, robuste Überwachungsmechanismen für bakterielle Infektionen einzuführen, insbesondere für Länder mit niedrigen und mittleren Einkommen.